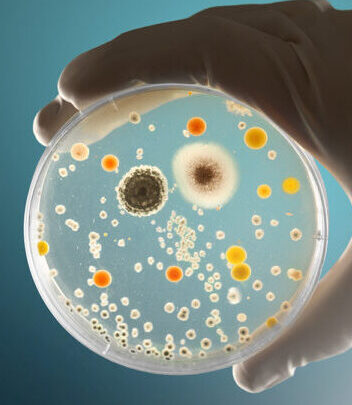

BIENVENIDOS A INTILABLaboratorio de Análisis Clínicos y Patología

BIENVENIDOS A INTILABLaboratorio de Análisis Clínicos
y Patología

SOBRE NOSOTROSMás de 10 años de experiencia de nuestros Profesionales que le asegurarán un resultado exacto, preciso, rápido y de calidad.
Nuestros procesos se adaptarán a sus necesidades y lo asistiremos respondiendo sus preguntas, ayudando a definir su diagnóstico y colaborando con un mejor tratamiento.
Desde su llamada telefónica inicial o consulta realizada a través de nuestro sitio web www.intilabperu.com notará la diferencia con INTILAB. Ofrecemos acceso directo a sus resultados desde la sección RESULTADOS EN LÍNEA, acceso a todos nuestros SERVICIOS, PROMOCIONES, respondemos sus dudas con nuestro staff de profesionales, aportando una mejora en su calidad de vida.